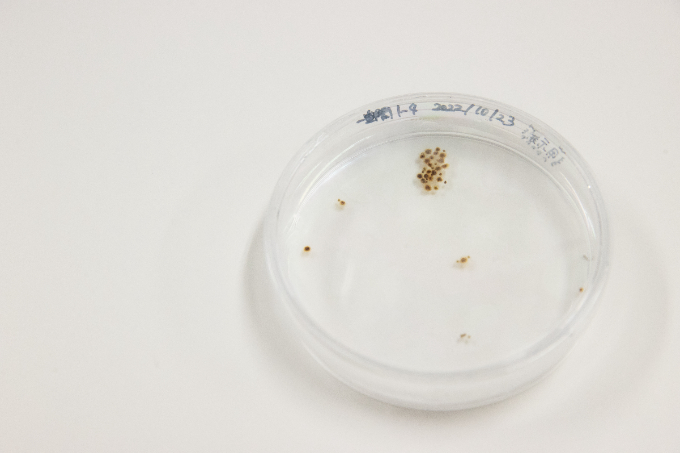

昆布と海がくれる、潤いの未来。いま、私たちにもできることは?
函館の海は、いつの時代も人々の暮らしを支えてきました。その象徴ともいえるのが昆布です。食卓を彩り、祝いの席にも欠かせないこの恵みは、いまでは美容の分野にも広がりを見せています。2025年9月にサラヤからリニューアル発売されるサステナブルヘアケアブランド『ココパーム』の「オーシャンエッセンス」シリーズにも、昆布由来の天然補修成分・ケルプエキスが取り入れられました。しかしその一方で、昆布をはじめとする海藻の生育環境は、気候変動の影響によって確実に失われつつあります。豊かな海が荒廃すれば、やがて地域の産業や人々の暮らしにも深刻な影響を及ぼします。急速に進む「海の砂漠化」を食い止めようと立ち上がった人々がいます。その想いと取り組みを伺いました。記事の後半では『ココパーム』のシャンプー&トリートメントのプレゼントもあり。お見逃しなく。

風光明媚な海の底で起こっている異変とは

市街地から車で東へ約1時間。たどり着いたのは恵山(えさん)の小さな港です。そこから船に揺られてわずか10分ほど沖へ出ると、海面一面にオレンジ色の浮き玉が点々と浮かんでいました。その不思議な光景に見入っていると、船を操縦していた漁師の岸本眞彦さんが静かに口を開きます。
「ここでは真昆布を養殖しています。実は尻岸内(しりきない)地区では2〜3年前から天然の昆布がほとんど獲れなくなり、昨年はついにゼロになってしまいました。大事な収入源を守るために、私たちは数年前から養殖へと切り替えたのです」。
「ここでは真昆布を養殖しています。実は尻岸内(しりきない)地区では2〜3年前から天然の昆布がほとんど獲れなくなり、昨年はついにゼロになってしまいました。大事な収入源を守るために、私たちは数年前から養殖へと切り替えたのです」。

自身も昆布の生産者である岸本さんは、この海を38年間見つめ続けてきました。そんな彼が異変に気付いたのは、いまから5年ほど前のこと。
「この船が停まっている辺りは、一面が天然の昆布で覆われていたんですよ。それが2020年ごろから目に見えて減り始め、ついにはスジメのような雑海藻すら消えてしまったんです」。
「この船が停まっている辺りは、一面が天然の昆布で覆われていたんですよ。それが2020年ごろから目に見えて減り始め、ついにはスジメのような雑海藻すら消えてしまったんです」。

天然の真昆布や雑海藻が、なぜ海底から姿を消してしまったのか。理由を岸本さんに尋ねました。
「2016年に起きた爆弾低気圧の時化で、昆布も雑海藻もすべて流されてしまったんです。地元では『浜洗い』と呼んでいますが、完全に無くなるなんてことは、これまでなかった」
それでも翌年には、わずかに昆布が育ったといいます。けれども、今ではその光景すら見られません。成長を阻む、思いがけない存在が増えてしまったからです。
「2016年に起きた爆弾低気圧の時化で、昆布も雑海藻もすべて流されてしまったんです。地元では『浜洗い』と呼んでいますが、完全に無くなるなんてことは、これまでなかった」
それでも翌年には、わずかに昆布が育ったといいます。けれども、今ではその光景すら見られません。成長を阻む、思いがけない存在が増えてしまったからです。

「捕食者であるウニが増え過ぎているんです。昆布が芽を出しても、食べ尽くされてしまい成長が追いつかない」
北海道特産のウニなら、市場に出回れば高級食材になるのでは?そんな疑問をぶつけると、岸本さんは首を横に振りました。
「数が増えすぎて、身が痩せているんです。だから味も良くない。商品としては成立しないんですよ」
北海道特産のウニなら、市場に出回れば高級食材になるのでは?そんな疑問をぶつけると、岸本さんは首を横に振りました。
「数が増えすぎて、身が痩せているんです。だから味も良くない。商品としては成立しないんですよ」

追い討ちをかけるように、事態をさらに悪化させている要因があります。
「海水温の上昇です。本来、肉厚の昆布がよく育つには2月の水温が1℃前後であることが理想です。ところが2025年は4〜8℃にまで上がってしまった。取材時(6月)では11℃ほどで、ちょうどよさそうに思えるかもしれませんが、平年より4〜5℃も高い。海が温まりすぎると、昆布は成長を止め、やがて枯れてしまうのです」
「海水温の上昇です。本来、肉厚の昆布がよく育つには2月の水温が1℃前後であることが理想です。ところが2025年は4〜8℃にまで上がってしまった。取材時(6月)では11℃ほどで、ちょうどよさそうに思えるかもしれませんが、平年より4〜5℃も高い。海が温まりすぎると、昆布は成長を止め、やがて枯れてしまうのです」

昆布の生産量・生産高で日本一を誇る函館。その海で起きている異変に、岸本さんは声を震わせます。そして、彼の悲痛な叫びを耳にして、「海の宝」を守ろうと立ち上がった人がいました。
海底に広がる命の森、昆布が守る生きものたち

「海に潜って、1日で1万個以上のウニを取り除きました。それでも追いつかないんです」
そう語るのは、北海道大学の海洋科学博士・秋田晋吾助教。岸本さんからのSOSを受け、共に藻場の再生に挑むようになりました。昨年秋には2人で恵山の海に潜り、ひたすらウニを取り除く作業を実施。ちなみに岸本さんは、単独で潜った際にも1万個近いウニを陸へ上げているのだそうです。
そう語るのは、北海道大学の海洋科学博士・秋田晋吾助教。岸本さんからのSOSを受け、共に藻場の再生に挑むようになりました。昨年秋には2人で恵山の海に潜り、ひたすらウニを取り除く作業を実施。ちなみに岸本さんは、単独で潜った際にも1万個近いウニを陸へ上げているのだそうです。

ここまで話を聞いていると、ふと素朴な疑問が浮かびます。そもそも「藻場」とは何なのでしょうか。そして、どんな役割を持っているのでしょう?
「藻場とは、海藻や海草が生い茂る場所で、『海の森』とも呼ばれます。特に昆布やヒジキなどの大型の海藻が集まる一帯では、魚やイカが産卵することもあり、多様な生物を育むゆりかごのような役割を果たしています。それだけでなく、食糧を提供したり、水を浄化したり、波の力を弱める働きもあります。なかでも最近注目されているのがブルーカーボンです。昆布などの海藻はCO2を吸収し、海底や深海に炭素を蓄積します。その吸収量を数値化し、企業が購入することで、得られた収入は藻場の保全資金として活用されることもあるのです」
「藻場とは、海藻や海草が生い茂る場所で、『海の森』とも呼ばれます。特に昆布やヒジキなどの大型の海藻が集まる一帯では、魚やイカが産卵することもあり、多様な生物を育むゆりかごのような役割を果たしています。それだけでなく、食糧を提供したり、水を浄化したり、波の力を弱める働きもあります。なかでも最近注目されているのがブルーカーボンです。昆布などの海藻はCO2を吸収し、海底や深海に炭素を蓄積します。その吸収量を数値化し、企業が購入することで、得られた収入は藻場の保全資金として活用されることもあるのです」
昆布の生態に魅せられ、研究を続ける秋田助教。函館の海が直面している厳しい現状について、こう語ります。
「藻場の減少は『磯焼け』と呼ばれています。この言葉はここ数年、函館だけでなく各地で藻場が失われる中で広く知られるようになりました。決して喜ばしいことではありません。僕が学生だった10数年前は、専門家以外はほとんど耳にしない言葉でしたからね。実際、海に潜る現場で『STOP 磯焼け』と書かれたTシャツを着ていると、『磯での日焼けは大変ですものね』と声をかけられたこともありました。それほど認知されていなかったのです。でも今は違います。多くの人がその意味を理解しています」
さらに続けます。
「最近では、かつての環境を取り戻すための活動も行われています。ただ、思うように進んでいないのが現状です。ウニの除去や藻場の手入れをするには、海に潜らなければなりませんが、その予算を確保するのは簡単ではありません。捕食者の増殖スピードを抑えるのは、本当に至難のワザです。藻場の減少は漁業の衰退も加速させます。地域の暮らしを守るためにも、食い止めなければなりません。同時に、まだ解明されていない昆布の可能性についても調査を進めています」
「藻場の減少は『磯焼け』と呼ばれています。この言葉はここ数年、函館だけでなく各地で藻場が失われる中で広く知られるようになりました。決して喜ばしいことではありません。僕が学生だった10数年前は、専門家以外はほとんど耳にしない言葉でしたからね。実際、海に潜る現場で『STOP 磯焼け』と書かれたTシャツを着ていると、『磯での日焼けは大変ですものね』と声をかけられたこともありました。それほど認知されていなかったのです。でも今は違います。多くの人がその意味を理解しています」
さらに続けます。
「最近では、かつての環境を取り戻すための活動も行われています。ただ、思うように進んでいないのが現状です。ウニの除去や藻場の手入れをするには、海に潜らなければなりませんが、その予算を確保するのは簡単ではありません。捕食者の増殖スピードを抑えるのは、本当に至難のワザです。藻場の減少は漁業の衰退も加速させます。地域の暮らしを守るためにも、食い止めなければなりません。同時に、まだ解明されていない昆布の可能性についても調査を進めています」
がごめ昆布の粘りが切り拓く、海の未来産業

漁業によって繁栄してきた函館。その暮らしを守るために、産学官が一丸となって昆布の新たな可能性を探っています。その中心を担うのが北海道マリンイノベーションです。営業部長の梅津彰さんに取り組みを伺いました。
「北海道大学の安井肇特任教授らが開発した『北大ガゴメ』の普及に取り組んでいます。通常は18ヶ月かかる養殖期間を、わずか6ヶ月に短縮することに成功しました。また、がごめ昆布最大の特徴である粘り成分フコダインの含有量を、天然の2倍以上に高めることにも成功しています」
「北海道大学の安井肇特任教授らが開発した『北大ガゴメ』の普及に取り組んでいます。通常は18ヶ月かかる養殖期間を、わずか6ヶ月に短縮することに成功しました。また、がごめ昆布最大の特徴である粘り成分フコダインの含有量を、天然の2倍以上に高めることにも成功しています」

「このフコダインエキスは、髪や肌の保湿に優れています。その力に着目したサラヤさんが『ココパーム オーシャン』の保湿成分のひとつとして採用してくれました。がごめ昆布の生産量が増えると、漁師の収入が安定し、地域経済の活性化にもつながります。フコイダンエキスは、美と健康を支えるだけでなく、地域の未来を育む大切な存在なのです」
100年後も「こんぶの森」がある海をつなぐ

「たとえどんなに小さなことでも、できることはやります。その行動が、北海道の豊かな海を未来へつなげると信じているからです」
そう語るのは、「海とこんぶの森プロジェクト」を主導するWMIの伊藤慶子さん。北海道庁で約18年、水産専門職として水産業と海洋環境の保全に携わってきました。休日には道内の漁師のもとを訪れ、海産物の魅力を発信。その過程で、昆布が激減していく現状を目の当たりにしたことが、伊藤さんの行動の原点となります。
悲しい現実を変えたいという思いから道庁を退職し、2019年に起業。以来、漁師や自治体、学者らと協力しながら、藻場の再生計画を推進しています。
そう語るのは、「海とこんぶの森プロジェクト」を主導するWMIの伊藤慶子さん。北海道庁で約18年、水産専門職として水産業と海洋環境の保全に携わってきました。休日には道内の漁師のもとを訪れ、海産物の魅力を発信。その過程で、昆布が激減していく現状を目の当たりにしたことが、伊藤さんの行動の原点となります。
悲しい現実を変えたいという思いから道庁を退職し、2019年に起業。以来、漁師や自治体、学者らと協力しながら、藻場の再生計画を推進しています。

「2023年10月に、『海とこんぶの森プロジェクト』をスタートしました。活動は大きく3つの柱から成り立っています。まず1つ目は、藻場の再生です。岸本さんや秋田助教と協力し、失われつつある海の生態系を取り戻す取り組みを進めています。2つ目は、循環型粘土を活用した環境教育です。子どもたちが自分でつくった粘土作品を海の中で観察する体験を通じて、海の現状を自分の目で確かめます。潜った先に広がるのは、かつて藻場があったエリアにウニが異常繁殖する光景。海が直面する異変を実感することで、自然を守る意識や関心が芽生えます。そして3つ目は、海藻を活用した商品の企画・開発です。私たちはサラヤさんが主宰する、海洋資源の持続可能な活用と海洋生態系の保護を目指す『ブルーオーシャンイニシアチブ』に参加し、フコダインエキスを提案しました。その理念に共感していただき、『ココパーム オーシャン』の原料として採用されることに。社会課題の解決と持続可能な製品づくりに取り組むサラヤさんのサポートを得て、藻場再生という壮大なビジョンは、着実に現実的な計画へと進化しています」

天然洗浄成分・ソホロを主役にした「ココパーム オーシャン」には、函館で育まれたがごめ昆布エキスをはじめ、廃棄されるはずだったマリンエキスやパールエキスを配合されています。さらに、売上の一部は「海とこんぶの森プロジェクト」へ寄付され、海の砂漠化を食い止める活動に役立てられます。
バスルームで髪と心を健やかに整えながら、かけがえのない自然を守る力になれる。あなたの選択で未来を変えてみませんか。
バスルームで髪と心を健やかに整えながら、かけがえのない自然を守る力になれる。あなたの選択で未来を変えてみませんか。
【現品30名様に】地肌と髪を健やかに導くシャンプー&トリートメントをプレゼント

“あなたと地球を美しく”をコンセプトに生まれ変わった、サステナブルヘアケアブランド『ココパーム』。その「オーシャンエッセンス」シリーズには、函館の海で育まれた昆布から抽出したケルプエキスを配合。高い保湿力で、なめらかにまとまり、しっとり落ち着いた髪へと導きます。
今回、「ココパーム オーシャンエッセンス シャンプー/トリートメント」と「ココパーム ランドエッセンス シャンプー/トリートメント」の現品4点セットを、抽選で30名様にプレゼント! 地肌にも髪にも、そして地球にもやさしいヘアケアを、この機会にぜひ体験してみてください。
■プレゼント内容
・ココパーム オーシャンエッセンス シャンプー(現品)
・ココパーム オーシャンエッセンス トリートメント(現品)
・ココパーム ランドエッセンス シャンプー(現品)
・ココパーム ランドエッセンス トリートメント(現品)
■商品詳細
ヤシの実由来の天然洗浄成分ソホロを配合した、サステナブルヘアケアブランド「ココパーム」が待望のリニューアル。髪の仕上がりに合わせて選べる2ラインを展開しています。
・オーシャンエッセンス―あなたと海を美しく:なめらかで落ち着いたまとまる髪へ
・ランドエッセンス―あなたと大地を美しく:しなやかで根本からふんわりした髪へ
■当選者数
30名様
■応募方法
以下のフォームよりご応募ください。
今回、「ココパーム オーシャンエッセンス シャンプー/トリートメント」と「ココパーム ランドエッセンス シャンプー/トリートメント」の現品4点セットを、抽選で30名様にプレゼント! 地肌にも髪にも、そして地球にもやさしいヘアケアを、この機会にぜひ体験してみてください。
■プレゼント内容
・ココパーム オーシャンエッセンス シャンプー(現品)
・ココパーム オーシャンエッセンス トリートメント(現品)
・ココパーム ランドエッセンス シャンプー(現品)
・ココパーム ランドエッセンス トリートメント(現品)
■商品詳細
ヤシの実由来の天然洗浄成分ソホロを配合した、サステナブルヘアケアブランド「ココパーム」が待望のリニューアル。髪の仕上がりに合わせて選べる2ラインを展開しています。
・オーシャンエッセンス―あなたと海を美しく:なめらかで落ち着いたまとまる髪へ
・ランドエッセンス―あなたと大地を美しく:しなやかで根本からふんわりした髪へ
■当選者数
30名様
■応募方法
以下のフォームよりご応募ください。



























![満期時にはうれしいボーナス。[スゴ積み]で始める。自...](https://d2u2p93rbjj5dq.cloudfront.net/assets/uploads/2025/12/FotoJet-11-150x150.jpg)

















